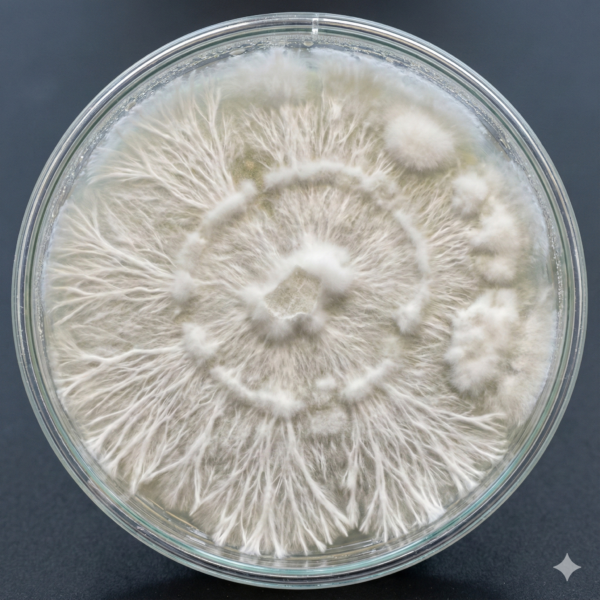
Mazatapec Mycelium

Connect with the roots of the psychedelic renaissance. Mazatapec is the strain that introduced the Western world to the magic of mushrooms, yet it remains untamed and resilient. Our Premium Grow Kit features vigorous, contaminant-free mycelium sourced directly from the lineage of the Oaxaca mountains.
This is a strain for the patient observer. While it may colonize with the deliberation of a sage, it rewards the researcher with prolific flushes of stunning, golden-capped fruit bodies. Renowned for its biological resilience and unique aesthetic, Mazatapec is an essential addition to any premium collection.
-
Grade: Premium (Selected Genetics)
-
Character: Resilient, Spiritual, Abundant
-
Origin: Mexico (Oaxaca)

Reviews
There are no reviews yet.